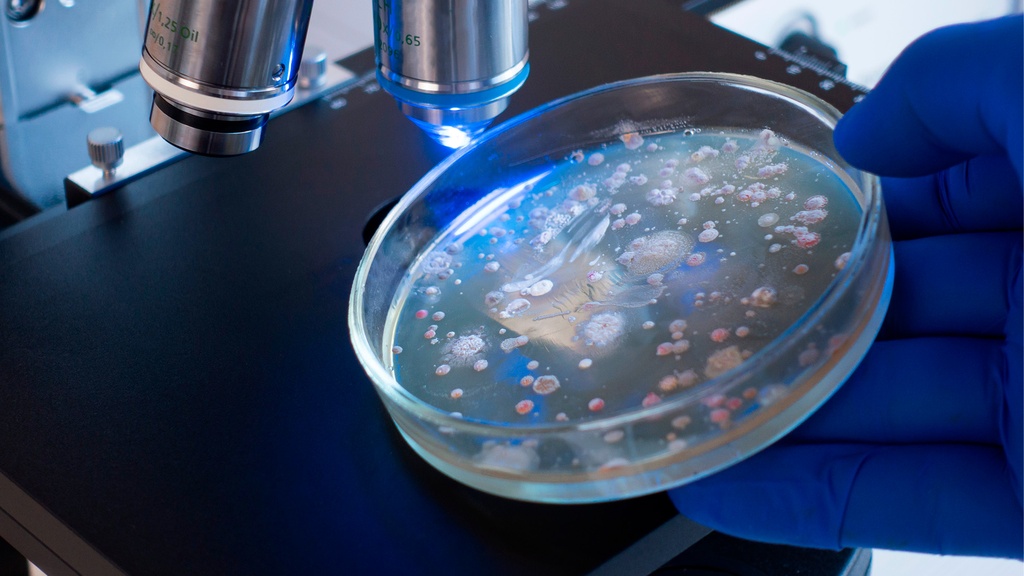
Coproparasitoscópico 1 Muestra

Coproparasitoscópico 1 Muestra
Recolectar en un frasco limpio una muestra de materia fecal del tamaño de una nuez (5 g), etiquetarla con fecha y nombre completo. Entregarla al laboratorio sin tener más de 24 hrs de ser emitida.
Tiempo de Entrega: 1 día hábil
NO